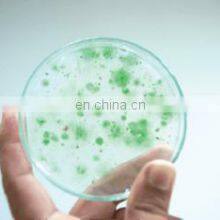
Laboratory High Pressure Homogenizer thumbnail-4
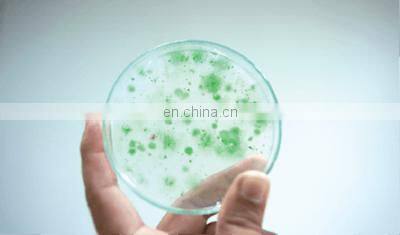
Laboratory High Pressure Homogenizer photo-4

Patent Number:ZL200910099490.4
The highest pressure of JG-IA is 256Mpa (37120PSi), which can satisfy many cell wall breaking and nano
homogenization / dispersion of sample, and realize effective temperature control at the same time
HIGH PRESSURE HOMOGENIZER 8435 High pressure homogenizer using the material in the special
role of plunger into the valve which it is adjustable pressure, after a certain width limiting slot (work
area), transient voltage loss of material at high velocity (1000-1500 M / sec)..
Maximum working pressure | 1200bar/120Mpa/17400PSI |
Maximum design pressure | 1500bar/150Mpa/21750PSI |
Maximum capacity | 12/L,25L/H,two models machine |
Minimum capacity | 30ml |
Cooling | Built-in cooler |
Motor power | 1500W/380V/50Hz |
Dimensions | 800*460*450mm |
Weight | 120KG |
Sample example | ||||||||
Plant protein | Soybean protein, peanut protein, sweet potato protein, etc | |||||||
Plant tissue | Tremella spores, hawthorn leaves, loquat leaves, rhizomes of ginger plants, etc | |||||||
Algal cells | Spirulina Cells, Candida hair cells, Chlorella cells, etc | |||||||
Microorganism | Yeast, Escherichia coli, schizosporum, etc | |||||||
Liquid food | Food and beverage, dairy products, jelly, etc | |||||||
Paint paste | Carbon black paint paste, phthalocyanine green paint paste, phthalocyanine blue paint paste, purple 23 paint paste, etc | |||||||



Send Inquiry to This Supplier
You May Also Like
-
Stacked Sludge DewateringNegotiableMOQ: 1 Set
-
Food Grade Liquid Mixing Tank Designed for Beverage and Dairy Production IndustriesNegotiableMOQ: 1 Unit
-
GYC Production Line of SoapNegotiableMOQ: 1
-
Multi Tube Vortex Mixer Laboratory MixerUS$ 753 - 753MOQ: 1 Piece
-
JHS2000 Mixer Double Movement Powder Mixer for Fine Powder, Superfine PowderUS$ 10,000 - 15,000MOQ: 1 Set
-
China Dry Mortar Zenamix Powder Mix Plant, Pigment Powder Mixing Machine for Making DetergentUS$ 800 - 1,500MOQ: 1 Set
-
Brightway Jet Mud Mixer of Solids Control SystemNegotiableMOQ: 1 Set
-
Fertilizer Manure Blender MixerUS$ 3,000 - 35,000MOQ: 1 Set
-
DJM Serie High Speed HomogenizerUS$ 1,000 - 5,000MOQ: 1 Unit
-
Industrial Horizontal Animal Ribbon Blender Dry Poultry Cattle Feed Mixer, Powder Mixer, Blender MixerUS$ 20,900 - 47,000MOQ: 1 Set